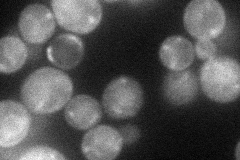
YPL072W
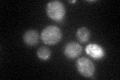
YPL072W

View description
Deubiquitinating enzyme anchored to the outer mitochondrial membrane, probably not important for general mitochondrial functioning, but may perform a more specialized function at mitochondria
Localization:
Intensity:
Fold change:
Significance:
-
C’ GFP library in SD

mitochondria18.76 -
N' NOP1pr-GFP in SD
cell periphery,punctate48.066 -
N' TEF2pr-mCherry in SD

missing0 -
N' NATIVEpr-GFP in SD

below threshold20.4829 -
N' TEF2pr-VC and Cyto-VN in SD

#N/A0 -
C’ GFP library in SD+DTT
mitochondria22.241.18No -
C’ GFP library in SD+H2O2

mitochondria18.530.98No -
C’ GFP library in Starvation Media

mitochondria17.340.92No -
C’ GFP library on the background of Pup2-DaMP

mitochondria -
C’ GFP library on the background of CCT mutant

mitochondria20.96921.11718No
